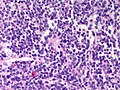
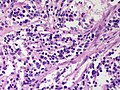

Neuroblastoma
Jump to navigation
Jump to search
Neuroblastoma is a malignant tumour of the adrenal gland.
Olfactory neuroblastoma is dealt with separately.
General
Epidemiology:
- Usually paediatric population.
Laboratory findings:
- Increased urine homovanillic acid.
Imaging:
- mIBG uptake (>90% neuroblastomas)
Predictors of a poor prognosis:[1]
- High mitotic-karyorrhectic index.
- Lack of schwannian stroma.
- >18 months.
- Near ploidy.
- N-MYC amplification.
- 1p deletion /imbalance
- Lymph node spread.
- Distant spread.
Classification:
- In a grouping known as neuroblastic tumours which includes:[2]
- Ganglioneuroma (benign).
- Ganglioneuroblastoma (intermediate).
- Neuroblastoma (aggressive).
Gross
- Typically an abdominal mass.
- ~40% arise in the adrenal gland.[3]
Microscopic
Features:[4]
- Small round blue cells separated by thin (pink) fibrous septa.
- Homer-Wright rosettes.
- Rosette with a small (~100 micrometers - diameter) meshwork of fibers (neuropil) at the centre.[5]
- Neuropil-like stroma = paucicellular stroma with a cotton candy-like appearance; see comparison below.
- >50% neuropil-like stroma -- otherwise it's a ganglioneurona or ganglioblastoma.
Notes:
- The fibrous septa are especially useful for differentiation from lymphoma.
DDx:
- Small round cell tumours.
- Wilms tumour.
- Lymphoma.
- Hepatoblastoma.
Images
Schwannian vs. neuropil
| Feature | Schwannian | Neuropil |
| Cellularity | high ~ spacing of cells < 30 µm | low ~ spacing of cells > 100 µm |
| Fibrillary | yes, long fine strands | no |
| Associations | ganglion cells | neuroblasts |
| Cytoplasmic vacuolation | yes | ? |
Classification/grading
Commonly grouped by the Shimada classification, which depends on the presence a number of things including:
- Mitoses/karyorrhectic cells.
- Molecular abnormalities.
International Neuroblastoma Risk Group Staging System (INRGSS)
- L1: Locoregional tumor without Image-Definging Risk factors (IDRFs)
- L2: Locoregional tumor with one or more IDRFs
- M: Distant metastatic disease (except Ms)
- Ms: INRG Stage L1 or L2 tumor with metastatic disease confined to skin and/or liver and/or bone marrow and age below 18 months.
IHC
- PGP 9.5 +ve.[7]
- PGP = protein gene product.
- NB-84 +ve.[8]
- More sensitive that synaptophysin.
- Synaptophysin +ve.
- CD99 -ve.
EM
Distinctive EM appearance:[9]
- Dendritic processes with longitudinally oriented microtubules.
- Membrane bound electron-dense granules (contain catecholamines).
- Desmosomes
- Membrane densities.
Pertinent negative:[9]
- No glycogen.
- Seen in EWS.
See also
References
- ↑ Mitchell, Richard; Kumar, Vinay; Fausto, Nelson; Abbas, Abul K.; Aster, Jon (2011). Pocket Companion to Robbins & Cotran Pathologic Basis of Disease (8th ed.). Elsevier Saunders. pp. 254. ISBN 978-1416054542.
- ↑ Shimada H, Ambros IM, Dehner LP, Hata J, Joshi VV, Roald B (July 1999). "Terminology and morphologic criteria of neuroblastic tumors: recommendations by the International Neuroblastoma Pathology Committee". Cancer 86 (2): 349–63. PMID 10421272.
- ↑ Mitchell, Richard; Kumar, Vinay; Fausto, Nelson; Abbas, Abul K.; Aster, Jon (2011). Pocket Companion to Robbins & Cotran Pathologic Basis of Disease (8th ed.). Elsevier Saunders. pp. 253. ISBN 978-1416054542.
- ↑ Chung EM, Murphey MD, Specht CS, Cube R, Smirniotopoulos JG (2008). "From the Archives of the AFIP. Pediatric orbit tumors and tumorlike lesions: osseous lesions of the orbit". Radiographics 28 (4): 1193–214. doi:10.1148/rg.284085013. PMID 18635637.
- ↑ Wippold FJ, Perry A (March 2006). "Neuropathology for the neuroradiologist: rosettes and pseudorosettes". AJNR Am J Neuroradiol 27 (3): 488–92. PMID 16551982.
- ↑ URL: http://radiographics.rsna.org/content/28/4/1193.full. Accessed on: 12 January 2011.
- ↑ Ootsuka, S.; Asami, S.; Sasaki, T.; Yoshida, Y.; Nemoto, N.; Shichino, H.; Chin, M.; Mugishima, H. et al. (Jun 2008). "Useful markers for detecting minimal residual disease in cases of neuroblastoma.". Biol Pharm Bull 31 (6): 1071-4. PMID 18520032.
- ↑ Miettinen, M.; Chatten, J.; Paetau, A.; Stevenson, A. (Mar 1998). "Monoclonal antibody NB84 in the differential diagnosis of neuroblastoma and other small round cell tumors.". Am J Surg Pathol 22 (3): 327-32. PMID 9500774.
- ↑ 9.0 9.1 Mackay, B.; Masse, SR.; King, OY.; Butler, J. (Dec 1975). "Diagnosis of neuroblastoma by electron microscopy of bone marrow aspirates.". Pediatrics 56 (6): 1045-9. PMID 1196755.